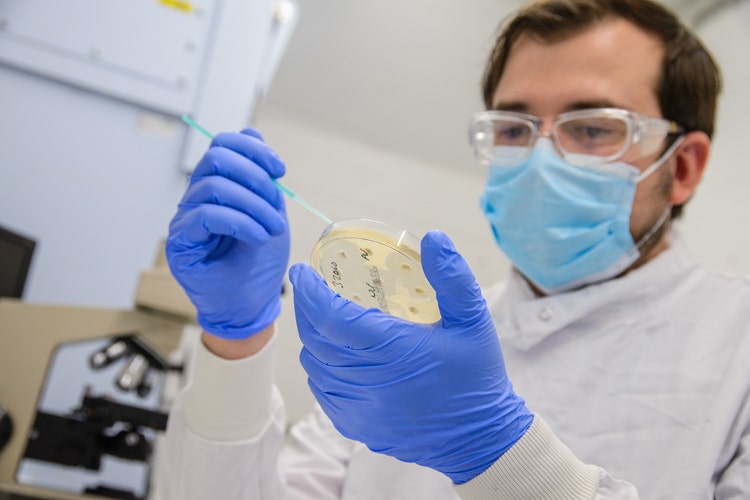

CVS opens 2024 funding applications for its unique Clinical Research Grants
2xl
2024-06-17
base
Research
transparent
medium
false
right-aligned
white
CVS has opened applications for academics at universities or research institutes to apply for its annual Clinical Research Grants.
Launched in 2021, CVS’ clinical research grants were a first in the profession and its funding is unique in the industry.
The group will fund veterinary clinical research that benefits animals under veterinary care, and research that supports the veterinary profession in providing the best possible care to animals. All funded research needs to demonstrate a clinical benefit and future impact upon veterinary practice.
This year’s scope of funding for universities or research institutes will focus solely on research supporting antibiotic stewardship across the veterinary profession. Applications should demonstrate a route to support responsible antibiotic prescribing, or infection prevention and control processes. Themes could include; the development of novel diagnostic or sequencing methods to support antibiotic prescribing; the development and evaluation of prescribing interventions; or the assessment of behavioural barriers or facilitators to implement effective infection control processes.
Funding is being made available to support one PhD of up to £30,000 per annum for a maximum of three years.
Alongside this latest funding call to academics, CVS are supporting multiple research projects being undertaken across the business specifically relating to antimicrobial stewardship. Additionally as part of CVS’ research support, all CVS residents are also automatically eligible to receive up to £5,000 to contribute to research that is required as part of their board accreditation.
Imogen Schofield, Director of Clinical Research at CVS, said:
“Clinical research is critical to generate new evidence that supports us in providing the best care. We want to foster a research-positive culture that drives change through a generation of new knowledge. For this year’s research funding we have set a clear priority, for both our internal projects and external research grants, to focus our research efforts and maximise their potential impact. This year’s priority is funding research to support antimicrobial stewardship within the veterinary profession - as we understand that antimicrobial resistance is one of the key global public health threats of our time.”
Applications are open until 30th August. Once received, they will be reviewed and scored by members of the CVS Clinical Research Panel on quality and study design, clinical impact and expected productivity. A shortlist will be communicated by 11th October 2024, with shortlisted applicants invited to join a panel meeting in November, before a final decision is made. The funded PhD studentship is then expected to commence in 2025.
More information about eligibility and the application process can be found in the CVS Research Grant section, or apply via email.
This year CVS Group has adopted a new Clinical Governance Framework; a system through which it holds itself accountable for improving the quality of its services and to cultivate a culture in which clinical care will continue to improve. Research and development is one of six pillars outlined in this framework highlighting the integral role that research and its outcomes, have in driving clinical improvement.